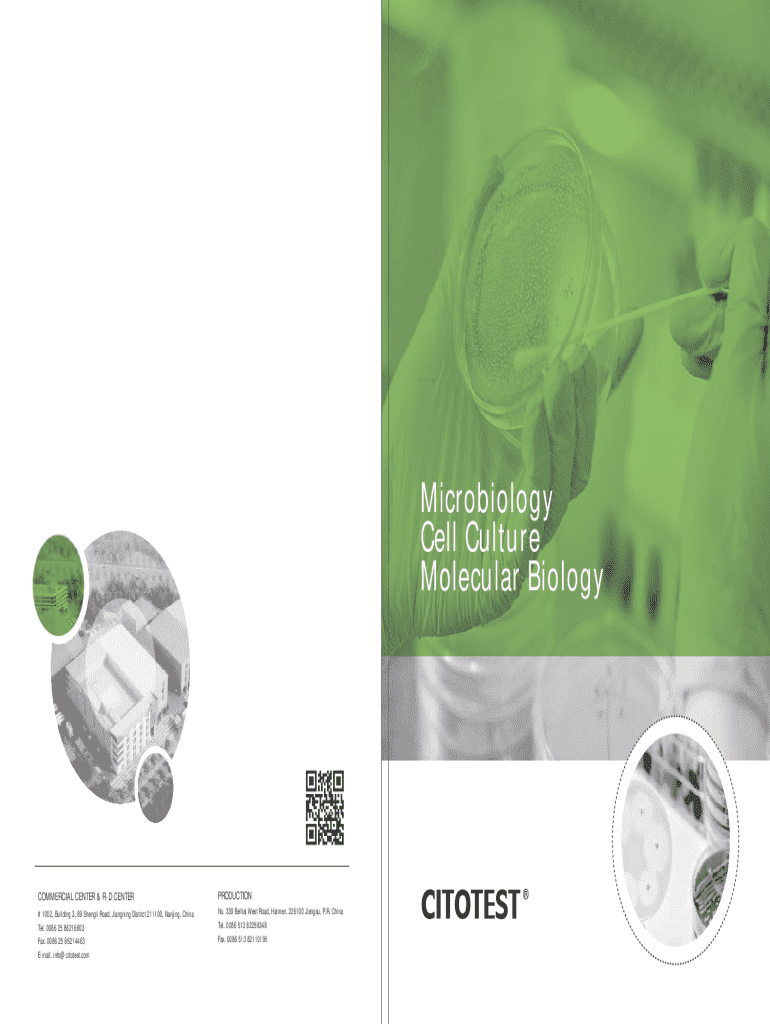

Get the free COMMERCIAL CENTER & R-D CENTER
Show details
Microbiology Cell Culture Molecular BiologyCOMMERCIAL CENTER & RD CENTERPRODUCTION#1002, Building 3, 89 Shengli Road, Jiangning District 211100, Nanjing, China Tel. 0086 25 86216803 Fax. 0086 25 86214463
We are not affiliated with any brand or entity on this form
Get, Create, Make and Sign commercial center r-d center

Edit your commercial center r-d center form online
Type text, complete fillable fields, insert images, highlight or blackout data for discretion, add comments, and more.

Add your legally-binding signature
Draw or type your signature, upload a signature image, or capture it with your digital camera.

Share your form instantly
Email, fax, or share your commercial center r-d center form via URL. You can also download, print, or export forms to your preferred cloud storage service.
Editing commercial center r-d center online
Here are the steps you need to follow to get started with our professional PDF editor:
1
Check your account. In case you're new, it's time to start your free trial.
2
Upload a document. Select Add New on your Dashboard and transfer a file into the system in one of the following ways: by uploading it from your device or importing from the cloud, web, or internal mail. Then, click Start editing.
3
Edit commercial center r-d center. Text may be added and replaced, new objects can be included, pages can be rearranged, watermarks and page numbers can be added, and so on. When you're done editing, click Done and then go to the Documents tab to combine, divide, lock, or unlock the file.
4
Save your file. Choose it from the list of records. Then, shift the pointer to the right toolbar and select one of the several exporting methods: save it in multiple formats, download it as a PDF, email it, or save it to the cloud.
It's easier to work with documents with pdfFiller than you could have believed. Sign up for a free account to view.
Uncompromising security for your PDF editing and eSignature needs
Your private information is safe with pdfFiller. We employ end-to-end encryption, secure cloud storage, and advanced access control to protect your documents and maintain regulatory compliance.
How to fill out commercial center r-d center

How to fill out commercial center r-d center
01
Gather all necessary documentation and information regarding the commercial center's objectives and requirements.
02
Outline the purpose of the R&D center, detailing the specific areas of research and development.
03
Assess the target market and determine the needs of potential customers.
04
Develop a budget that includes potential expenses, funding sources, and expected revenue.
05
Compile a list of required resources, including facilities, technology, and personnel.
06
Create a timeline for the development and implementation of the R&D center.
07
Fill out any required forms or applications required by local authorities or governing bodies.
08
Submit the completed application with all accompanying documentation.
Who needs commercial center r-d center?
01
Businesses looking to innovate and improve their products or services.
02
Investors seeking opportunities in emerging technologies and markets.
03
Government agencies aiming to support local economic development.
04
Startups needing research support to validate their business ideas.
05
Educational institutions looking to collaborate on applied research projects.
Fill
form
: Try Risk Free
For pdfFiller’s FAQs
Below is a list of the most common customer questions. If you can’t find an answer to your question, please don’t hesitate to reach out to us.
How can I send commercial center r-d center to be eSigned by others?
When you're ready to share your commercial center r-d center, you can send it to other people and get the eSigned document back just as quickly. Share your PDF by email, fax, text message, or USPS mail. You can also notarize your PDF on the web. You don't have to leave your account to do this.
How do I edit commercial center r-d center straight from my smartphone?
The easiest way to edit documents on a mobile device is using pdfFiller’s mobile-native apps for iOS and Android. You can download those from the Apple Store and Google Play, respectively. You can learn more about the apps here. Install and log in to the application to start editing commercial center r-d center.
How do I fill out commercial center r-d center on an Android device?
Use the pdfFiller mobile app to complete your commercial center r-d center on an Android device. The application makes it possible to perform all needed document management manipulations, like adding, editing, and removing text, signing, annotating, and more. All you need is your smartphone and an internet connection.
What is commercial center r-d center?
The commercial center R&D center is a facility or institution focused on research and development activities aimed at enhancing commercial activities, products, and services.
Who is required to file commercial center r-d center?
Businesses engaged in research and development activities within a commercial center are typically required to file the commercial center R&D center documentation.
How to fill out commercial center r-d center?
To fill out the commercial center R&D center, provide accurate information regarding the nature of research and development activities, expenses incurred, and outcomes achieved, following the guidelines set by regulatory authorities.
What is the purpose of commercial center r-d center?
The purpose of the commercial center R&D center is to foster innovation, improve competitive advantage, and drive economic growth through dedicated research and development efforts.
What information must be reported on commercial center r-d center?
Information that must be reported includes details of R&D projects, financial expenditures, personnel involved, and results achieved during the R&D process.
Fill out your commercial center r-d center online with pdfFiller!
pdfFiller is an end-to-end solution for managing, creating, and editing documents and forms in the cloud. Save time and hassle by preparing your tax forms online.
Commercial Center R-D Center is not the form you're looking for?Search for another form here.
Relevant keywords
Related Forms
If you believe that this page should be taken down, please follow our DMCA take down process
here
.
This form may include fields for payment information. Data entered in these fields is not covered by PCI DSS compliance.